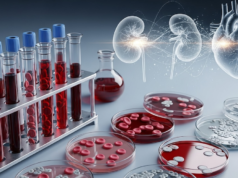
Eles descobriram que os marcadores de Alzheimer ajudam a prever doenças cardíacas e renais

Trent McDuffie era um jovem jogador do ensino médio no sul da Califórnia, depois de retornar de St. Louis para Los Angeles em 2016.
Durante o campo de treinamento do Rams naquele verão, McDuffie assistiu a um episódio da HBO de “Hard Knocks” sobre o time com seus pais, e eles ficaram impressionados com o técnico Sean McVay.
“Lembro-me de ter pensado: ‘Caramba, quero jogar para aquele cara’”, disse McDuffie na quinta-feira.
McDuffie, o cornerback All-Pro adquirido pelos Rams em uma negociação de grande sucesso, relembrou esses pensamentos durante uma coletiva de imprensa introdutória nas instalações do time em Woodland Hills, após assinar uma extensão recorde de quatro anos que supostamente inclui US$ 100 milhões em garantias.
“Avanço rápido ao longo dos anos e estou aqui e é apenas uma questão de tempo”, disse ele sobre jogar pelo McVay. “Olhei para esse cara, queria jogar para esse cara e agora esse cara me quer”.
Para se livrar de McDuffie, o gerente geral do Rams, Les Snead, enviou ao Kansas City Chiefs a 29ª escolha geral e a quinta e sexta rodadas do draft deste ano, e a terceira rodada em 2027.
Os Rams também assinaram com o ex-tight end Jaylen Watson um contrato de três anos com US$ 34 milhões garantidos.
A mudança decolou no ano passado, quando os Rams apostaram erroneamente que um pass rush jovem e agressivo poderia compensar sua decisão de não revisar o secundário.
Adicionando McDuffie e Watson a um elenco já profundo e talentoso que apresenta o jogador mais valioso da NFL, Matthew Stafford, os Rams serão os favoritos para jogar no Super Bowl LXI no SoFi Stadium em fevereiro.
E não se engane: assim como fizeram em 2021, os Rams farão todo o possível para garantir que o proprietário Stan Kroenke fique à margem do Super Bowl no estádio que construiu em Inglewood.
McDuffie observou que os Rams têm “batido na porta ano após ano” desde sua temporada de estreia com os Chiefs em 2022. Já existe uma cultura vencedora.
“Este time está pronto para ir”, disse McDuffie, escolhido no primeiro turno de Washington que jogou no ensino médio em Anaheim Servite e Bellflower St. “Não acho que vou entrar aqui com uma equipe que não entende o seu valor.
“Então, as pequenas pepitas que sinto que posso jogar nos caras que podem nos levar para a colina, farei o que puder.”
O cornerback do Rams, Jaylen Watson, fala durante sua conferência de posse em Woodland Hills na quinta-feira.
(William Liang/Associated Press)
McDuffie e Watson, escolhidos na sétima rodada de 2022, faziam parte de um time do Chiefs que ganhou dois campeonatos em três partidas no Super Bowl.
“Nós realmente aprendemos o que é preciso para ganhar um Super Bowl, chegar ao Super Bowl, a preparação e o tempo necessário para detalhar sua arte”, disse McDuffie.
Quando a notícia da negociação foi divulgada na semana passada, uma das primeiras ligações que McDuffie atendeu foi do receptor estrela do Rams, Puka Nacua, um ex-companheiro de equipe em Washington.
“Ele estava gritando a plenos pulmões”, disse McDuffie. “Eu estava tipo ‘Puka, mano, sinto falta dessa energia, sinto falta do que você traz.’ Estou feliz por estar de volta ao campo com ele.”
McDuffie e Watson também estão entusiasmados em continuar sua parceria, que começou quando eles estavam entre os cinco defensores convocados pelos Chiefs há quatro anos.
Watson, 27 anos, cresceu na Geórgia, mas jogou no Ventura College por duas temporadas antes de terminar sua carreira na Universidade de Washington.
Assim como McDuffie, ele está animado por estar de volta ao clima do sul da Califórnia.
“Todo mundo aqui é tão legal”, disse Watson sobre a área, antes de sussurrar: “você recebe seus impostos”.
O McDuffie de 5 pés-11 e o Watson de 6-2 fornecerão opções de confrontos para o técnico da segunda base Jimmy Lake – que treinou McDuffie na faculdade.
“É por isso que acho que Trent e eu nos complementamos tão bem”, disse Watson. “Seus pontos fortes são a rapidez em áreas curtas, os caras dos turnos pequenos, e meus pontos fortes são os wide receivers.
“Portanto, temos que ser versáteis. Temos que ser capazes de nos adaptar bem aos diferentes rostos que temos.”
McDuffie e Watson se juntam a um grupo de cornerbacks que inclui Emmanuel Forbes Jr. Os Rams têm até 1º de maio para determinar se exercerão uma opção de quinto ano na Forbes, uma escolha de primeira rodada do draft de 2023 por Washington que os Rams recusaram em 2024.
A Forbes ganhará cerca de US$ 2 milhões nesta temporada, mas terá US$ 12,6 milhões garantidos se os Rams exercerem a opção.
Os Rams começarão os treinos fora de temporada em abril.
McDuffie está feliz por estar de volta em casa.
“O tempo está quente, o sol está nascendo”, disse ele. “É uma coisa maravilhosa.”